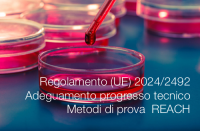

Regolamento (UE) n. 257/2010
| ID 13596 | | Visite: 2598 | Legislazione Chemicals | Permalink: https://www.certifico.com/id/13596 |
Regolamento (UE) n. 257/2010
Regolamento (UE) n. 257/2010 della Commissione, del 25 marzo 2010, che istituisce un programma relativo a una nuova valutazione degli additivi alimentari autorizzati conformemente al Regolamento (CE) n. 1333/2008 del Parlamento europeo e del Consiglio relativo agli additivi alimentari
GU L 80/19 del 26.3.2010
In allegato testo consolidato 02.2021 riservato abbonati contenente la seguente modifica:
- Regolamento di esecuzione (UE) 2021/148 della Commissione dell’8 febbraio 2021
Collegati
| Descrizione | Livello | Dimensione | Downloads | |
|---|---|---|---|---|
| Regolamento UE n. 257 2010 Testo consolidato 2021.pdf |
215 kB | 3 |